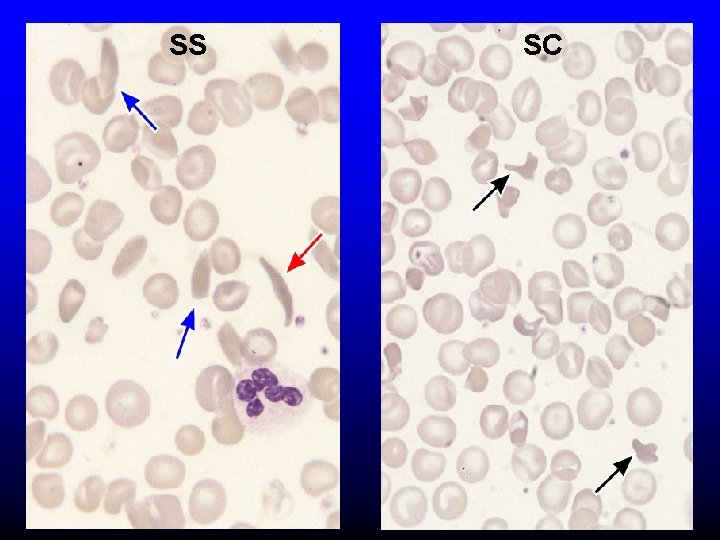
SS SC

Hemoglobin Synthesis Hemoglobin synthesis 25 0 5 1

Hemoglobin Synthesis

Hemoglobin synthesis 25% 0. 5% 1. 5% 48% a a g d b 25% 0. 5% 1. 5% 48% Chromosome 16 Chromosome 11

Hemoglobins in normal adults a b a g a d a Hb. A Hb. F Hb. A 2 98% ~1% <3. 5%

Hemoglobinopathy definition An inherited mutation of the globin genes leading to a qualitative abnormality of globin synthesis

Thalassemia definition An inherited mutation of the globin genes leading to a quantitative abnormality of globin synthesis

Geography of Hemoglobinopathies

Hemoglobin Electrophoresis Separation of various hemoglobins with electrophoresis on cellulose acetate, p. H 8. 6. Hemolysates represented are AA (normal adult), SC (hemoglobin SC disease), SSF (homozygous sickle disease, SS, with increased F), AS (sickle trait), and AC (C trait).

Hemoglobin Analysis by HPLC

Sickle Cell Anemia • Wide spectrum of disorders • 1 / 600 African Americans affected • 1 / 8 African Americans - sickle trait • Hb SS ~ 60% of sickle cell disease • Hb SC and Sb-thal ~ 40%

Sickle trait • • βS/β; 8% of African-Americans Asymptomatic Partial protection from malaria Sickling may occur in renal medulla → decreased urinary concentrating ability, hematuria • Rare complications at high altitude (splenic infarction) • Sudden death following strenuous exercise (rare)

Genetic and Laboratory Features of Sickle Hemoglobinopathies (Modified from Steinberg, M. , Cecil Medicine 2007)
SS SC

Pathophysiology of Sickle Cell Anemia Hb. S Polymer Vaso-occlusion Arginine NO Hemolysis (Modified from Steinberg, M. , Cecil Medicine 2007)

Sickle Cell: Molecular Basis • Glutamate Valine at 6 th position b globin • Sickle Hb forms polymers when deoxygenated • Polymerized sickle Hb injures RBC membrane and distorts its shape • Distorted RBC is hemolyzed

Sickle Cells – Electron Microscopy

Sickle Cell: Pathophysiology • Deoxygenation of mutant Hb leads to § K+ efflux § cell density / dehydration § polymerization • Sickled cells adhere to endothelial cells • Endothelial factors vasoconstriction • Blood flow promotes vaso-occlusion • “Vicious cycle” with decreased blood flow, hypoxemia / acidosis, increased sickling • Some cells become irreversibly sickled

FACTORS THAT INCREASE Hgb S POLYMERIZATION • Decreased oxygen • Increased intracellular hemoglobin S concentration (SS > SC, S-thal) • Increased 2, 3 -DPG • Decreased p. H • Slowed transit time through the circulation • Endothelial adhesion

FACTORS THAT DECREASE Hgb S POLYMERIZATION • Lower concentration of Hb S (compound heterozygosity for α thal) • Increased Hb. F levels – Genetic basis – Hydroxyurea

Clinical Features of Sickle Cell Anemia • Painful episodes • Renal abnormalities • Pneumococcal disease • Osteopenia • Acute chest syndrome • Nutritional deficiencies • Splenic infarction • Placental insufficiency • Splenic sequestration • Pulmonary hypertension • Stroke • Osteonecrosis • Priapism • Retinopathy • Leg ulcers • Gallstones

Clinical Features of Sickle Cell Anemia Associated with higher hemoglobin Associated with lower hemoglobin Painful episodes Acute chest syndrome Osteonecrosis Proliferative retinopathy Stroke Priapism Leg Ulcers

Complications of Sickle Cell Disease Pneumonia Skin ulcer Stroke Osteonecrosis

Sickle Cell – Avascular Necrosis gait. aidi. udel. edu/. . . /clcsimge/sickle 5 http: //www. zimmer. com

Sickle Cell – Avascular Necrosis http: //www. zimmer. com

Pulmonary Hypertension

Sickle Cell – Dactylitis http: //aapredbook. aappublications. org/week/116_09. jpg

Priapism

Sickle Cell – Splenic Complications Splenic Sequestration Autosplenectomy Sheth, S. et al Pediatr Radiol 2000 pathology. mc. duke. edu/. . . /spleen 1. jpg

Sickle Cell Anemia - treatment • • Opiates and hydration for painful crises Pneumococcal vaccination Retinal surveillance Transfusion for serious manifestations (eg stroke); exchange transfusion • Hydroxyurea • Stem cell transplant

Hemoglobin C • Glutamate → lysine at 6 th position in beta chain • Hb tends to crystallize • Prevalent in west Africa • Homozygous state – chronic hemolytic anemia • Compound heterozygosity with Hb S produces sickle phenotype

Hemoglobin C Homozygous: target cells, tactoids Hemoglobin SC

Other hemoglobinopathies • Unstable hemoglobins – Heinz body formation – Multiple mutations reported; dominant inheritance – Hemolytic anemia (may be precipitated by oxidative stress) Heinz bodies (supravital stain)

Other hemoglobinopathies • Hemoglobin M – Congenital methemoglobinemia, cyanosis • Hemoglobin with low oxygen affinity – Right shifted dissociation curve, decreased EPO – Mild anemia (asymptomatic) • Hemoglobin with high oxygen affinity – Left shifted dissociation curve, increased EPO – Erythrocytosis • These all have dominant inheritance • Many benign/asymptomatic mutations described

The Thalassemias Syndromes in which the rate of synthesis of a globin chain is reduced beta thalassemia - reduced beta chain synthesis alpha thalassemia – reduced alpha chain synthesis

THALASSEMIA • Diminished or absent synthesis of normal globin chains (α or β); genetically heterogeneous • Heterozygous state protects from malaria, hence more common in southern European, African, Asian peoples • Unbalanced globin chain synthesis causes microcytosis, ineffective erythropoiesis and hemolysis

Thalassemia

Single αglobin gene missing normal CBC Two α-globin genes missing: microcytosis, minimal anemia One β-globin gene missing: microcytosis, mild anemia Three αglobin genes missing: microcytosis, hemolysis, moderate to severe anemia Two β-globin genes missing: transfusiondependent anemia Decreasing globin chain production Increasing globin chain imbalance causing: • ineffective erythropoiesis (precipitated α chains) • hemolysis (β tetramers or Hb H) Worsening anemia Four αglobin genes missing: fetal demise

Alpha thalassemia aa / aaa / -a-/ -- Normal Mild microcytosis Hemoglobin H disease Hemoglobin Barts – Hydrops Fetalis

Hgb H disease H Hgb H inclusions (supravital stain)

Hydrops fetalis (note gross edema) Hydrops fetalis

Beta thalassemia major • No beta chain produced (no Hb. A) • Severe microcytic anemia occurs gradually in the first year of life (as gamma chain production stops) • Marrow expansion • Iron overload • Growth failure and death

Beta thalassemia major

Thalassemia

Beta thalassemia major Male 18 years

Beta thalassemia major treatment • Transfusion • Iron chelation • Stem cell transplant

Β-Thalassemia Minor • • b/ b 0 or b/ b+ Microcytosis, target cells Mild anemia – often asymptomatic Decreased Hb. A production → Increased proportion of Hb A 2

Β-Thalassemia Intermedia • b+/ b 0 (small amount of b chain production) • Chronic anemia • Splenomegaly • Often transfusion-dependent

Hemoglobin E • • • b mutation (glutamine → lysine at amino acid 26) Altered m. RNA splicing, unstable m. RNA Heterozygous in 30% of SE Asians Homozygous Hb E: microcytosis, hypochromia, little or no anemia Hemoglobin E / b-thal causes thalassemialike phenotype
- Slides: 47